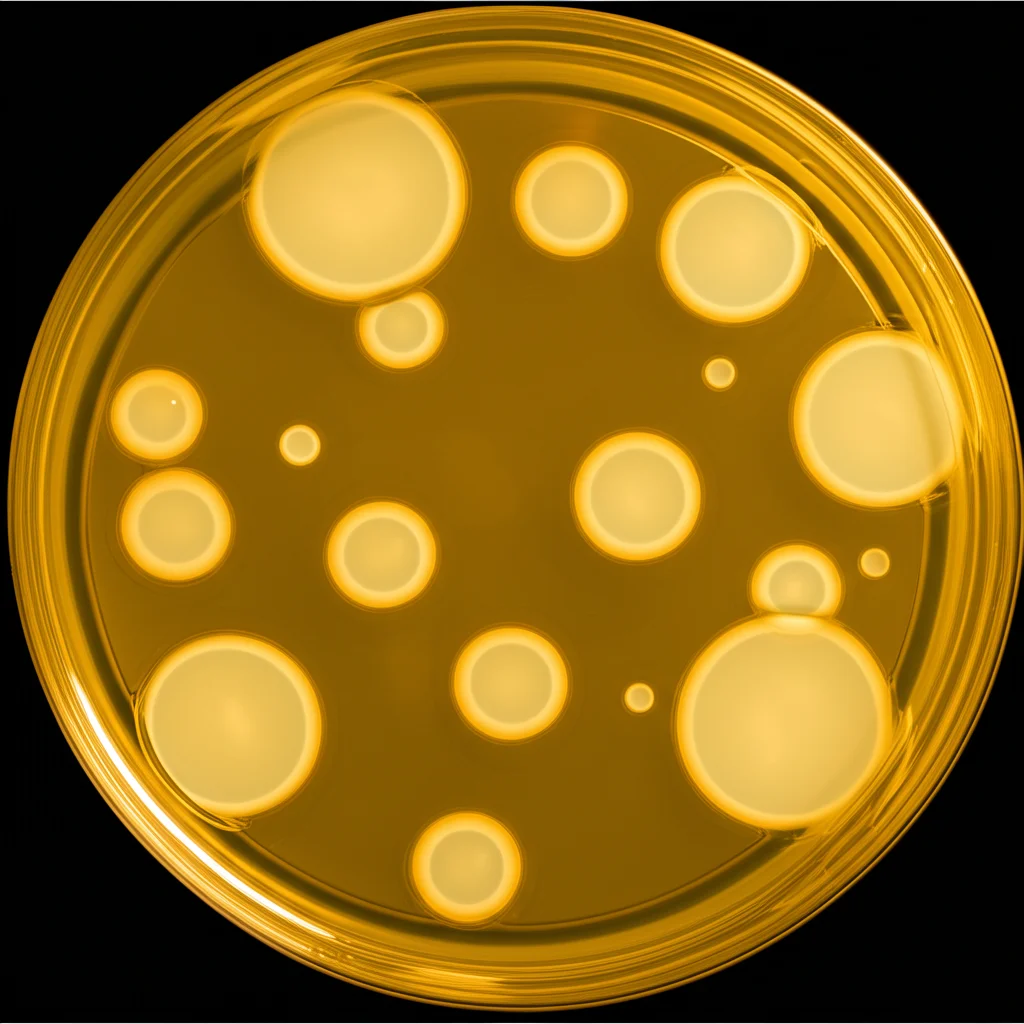
Fotografia macro (obiettivo 80mm) di una piastra di Petri con terreno di coltura agarizzato, che mostra zone circolari chiare (zone di inibizione) attorno a pozzetti contenenti il gel, indicando l'attività antibatterica contro Staphylococcus aureus, illuminazione dall'alto, alta definizione.

Addio Mal di Gola? La Rivoluzione del Gel ‘Intelligente’ all’Azitromicina!
Ciao a tutti! Oggi voglio parlarvi di qualcosa che mi appassiona moltissimo: come possiamo rendere i farmaci più efficaci e meno fastidiosi. Prendiamo ad esempio il mal di gola o le infezioni delle alte vie respiratorie (le cosiddette URTIs). Quante volte ci siamo trovati a combattere con faringiti, tonsilliti o quella fastidiosa sensazione di gola infiammata? Spesso, il medico ci prescrive un antibiotico, e uno dei più comuni è l’Azitromicina (ATM). È un’arma potente contro molti batteri, sia Gram-positivi che Gram-negativi, come lo Streptococcus pyogenes (il cattivo dietro al mal di gola streptococcico) o l’Haemophilus influenzae.
Il Problema dell’Azitromicina Tradizionale
Però, diciamocelo, l’Azitromicina non è perfetta. Ha un paio di “difetti” non da poco:
- Scarsa biodisponibilità orale: Quando la prendiamo per bocca, solo una parte (circa il 37%) viene effettivamente assorbita e arriva dove serve. Se poi la prendiamo col cibo, l’assorbimento può crollare addirittura del 50%!
- Effetti collaterali gastrointestinali: Mal di stomaco, diarrea, nausea, indigestione… chi ha preso l’ATM probabilmente sa di cosa parlo.
- Si “disperde” troppo: Ha un volume di distribuzione enorme, significa che tende ad accumularsi in vari tessuti del corpo, magari lontano dal sito dell’infezione (la nostra gola!), rendendo difficile concentrare l’azione dove serve davvero.
Questi problemi non solo riducono l’efficacia, ma aumentano anche il rischio di effetti collaterali e, a lungo andare, di sviluppare resistenze batteriche. Insomma, c’era bisogno di un’idea diversa!
L’Idea: Un Gel “Intelligente” e Mirato
E se potessimo portare l’Azitromicina direttamente lì dove serve, nella gola, facendocela rimanere per un po’ e rilasciandola gradualmente? Sarebbe fantastico, no? Meno farmaco in giro per il corpo, più concentrazione sull’infezione, meno effetti collaterali. È qui che entra in gioco la nostra ricerca. Abbiamo pensato: perché non creare un gel mucoadesivo? Un gel, cioè, capace di “attaccarsi” alla mucosa della gola. Ma non un gel qualsiasi. Un gel in situ.
Cosa significa “in situ”? Significa che la formulazione è liquida quando la applichiamo, ma si trasforma in gel una volta a contatto con l’ambiente specifico della gola, in questo caso grazie al pH fisiologico (intorno a 7.4). Immaginate una sorta di spray o liquido facile da applicare che, una volta arrivato a destinazione, “solidifica” leggermente diventando un gel appiccicoso. Comodo, vero?
Ma c’era un altro ostacolo: la solubilità dell’Azitromicina. Essendo poco solubile in acqua, come farla funzionare bene in un gel acquoso e farla rilasciare efficacemente? Qui entra in scena un altro protagonista: l’Idrossipropil-β-Ciclodestrina (HP-βCD). Pensate alle ciclodestrine come a delle minuscole “ciambelle” molecolari. La parte esterna è idrofila (ama l’acqua), mentre la cavità interna è lipofila (ama le sostanze grasse, come l’ATM). Inserendo l’Azitromicina dentro questa “ciambella”, creiamo un complesso di inclusione. Il risultato? La solubilità dell’ATM è schizzata alle stelle: ben 20 volte maggiore rispetto al farmaco puro! Un successo incredibile.

Sviluppo e Ottimizzazione: La Ricetta Perfetta
Una volta risolto il problema della solubilità creando il complesso ATM-HP-βCD (abbiamo usato un metodo chiamato “evaporazione del solvente” e confermato la formazione con tecniche come FT-IR, DSC e SEM che ci mostrano la struttura e le interazioni molecolari), ci siamo concentrati sul gel.
Volevamo un gel che fosse:
- pH-sensibile: Liquido a pH acido (come nella formulazione) e gel a pH neutro (come nella gola).
- Mucoadesivo: Capace di attaccarsi bene alla mucosa.
- Con le giuste proprietà reologiche: Non troppo denso da applicare, ma abbastanza viscoso da rimanere in posizione.
- Capace di rilasciare il farmaco in modo controllato.
Per trovare la “ricetta” perfetta, abbiamo usato un approccio moderno chiamato Quality-by-Design (QbD) e un disegno sperimentale specifico (Central Composite Design). Abbiamo giocato con le concentrazioni di due polimeri chiave: il Carbopol 934 (che aiuta a gelificare con l’aumento del pH) e il Chitosano (un polimero naturale biocompatibile che migliora la mucoadesione e la viscosità). Dopo vari esperimenti (ben 13 batch suggeriti dal software!), abbiamo trovato la combinazione ottimale: 0.3% di Carbopol e 0.5% di Chitosano.
Questa formulazione ottimizzata si è rivelata fantastica:
- Gelifica al pH giusto (6.7) e in un tempo ragionevole (circa 1.59 minuti).
- Ha una viscosità ideale (circa 1607.9 Pa.s a pH fisiologico).
- Si spalma bene (indice di spalmabilità 322.6%).
- Si “gonfia” assorbendo fluidi (indice di swelling del 98.26% dopo 10 ore), il che aiuta nel rilascio del farmaco.
- Ha una forza mucoadesiva eccellente (589 g/cm²), misurata con un texturometro su mucosa di gola di capra (un modello standard in vitro). Significa che si attacca davvero bene!

La Prova del Nove: Funziona Davvero?
Ok, il gel sembra promettente sulla carta e nei test preliminari, ma fa quello che deve fare? Rilascia il farmaco? Uccide i batteri? Rimane in gola?
Rilascio del Farmaco: Abbiamo testato il rilascio in vitro usando un metodo con membrana dialitica. Risultato? Il nostro gel ha rilasciato l’Azitromicina in modo sostenuto per 12 ore, arrivando a liberare circa il 94% del farmaco. Molto meglio del farmaco puro, che si rilascia molto più lentamente a causa della sua scarsa solubilità. Il complesso con ciclodestrina ha fatto davvero la differenza, soprattutto dopo le prime ore.
Attività Antimicrobica: Abbiamo sfidato il nostro gel contro uno dei batteri più comuni nelle infezioni della gola, lo Staphylococcus aureus.
- Test su piastra (Agar well diffusion): Il nostro gel ha creato un alone di inibizione della crescita batterica significativamente più ampio (31 mm) rispetto alla soluzione di farmaco puro. Questo significa maggiore potenza antibatterica locale.
- Minima Concentrazione Inibente (MIC): Abbiamo visto qual è la minima concentrazione di farmaco necessaria per bloccare la crescita batterica in brodo. Per il nostro gel, la MIC era di 1 µg/mL, mentre per il farmaco libero era di 3 µg/mL. Il nostro gel è risultato più efficace a concentrazioni inferiori!
Test In Vivo (su ratti): Abbiamo fatto un passo avanti, testando il gel su modelli animali (ratti albini maschi, seguendo tutte le linee guida etiche).
- Efficacia Antimicrobica: Abbiamo indotto un’infezione da Staphylococcus aureus nei ratti e poi li abbiamo trattati con il nostro gel o con una formulazione commerciale di ATM. Il nostro gel ha mostrato una riduzione significativamente maggiore della carica batterica nella gola rispetto alla formulazione standard. Questo è probabilmente dovuto alla maggiore permanenza del gel nel sito d’azione e al rilascio controllato.
- Tempo di Permanenza: Volevamo vedere per quanto tempo il gel rimanesse effettivamente nella gola. Abbiamo aggiunto un mezzo di contrasto (solfato di bario) al gel e abbiamo somministrato la formulazione ai ratti, scattando radiografie a diversi intervalli di tempo. Le immagini hanno mostrato che il gel aderiva alla mucosa della gola e rimaneva lì per un periodo prolungato, fino a 24 ore! Abbiamo anche misurato la quantità di farmaco rimasta con analisi HPLC su tamponi mucosali, confermando una presenza significativa anche dopo 12 ore (circa 21%) e tracce dopo 24 ore (circa 2%).

Conclusioni e Prospettive Future
Cosa ci dicono tutti questi risultati? Che abbiamo per le mani qualcosa di veramente promettente! Questo gel mucoadesivo in situ a base di complesso Azitromicina-HP-βCD sembra superare molti dei limiti dell’ATM tradizionale per le infezioni delle alte vie respiratorie.
I vantaggi principali sono:
- Maggiore solubilità e stabilità del farmaco grazie al complesso con ciclodestrina.
- Applicazione mirata direttamente nel sito dell’infezione (gola).
- Maggiore tempo di permanenza (fino a 24 ore) grazie alla mucoadesività.
- Rilascio controllato e prolungato del farmaco.
- Maggiore efficacia antimicrobica locale, come dimostrato dai test in vitro e in vivo.
- Potenziale riduzione degli effetti collaterali sistemici (anche se servono studi clinici per confermarlo).
Credo davvero che questo approccio di delivery localizzato possa rappresentare una strategia vincente per migliorare l’efficacia terapeutica dell’Azitromicina contro le URTIs, rendendo il trattamento più efficace e, speriamo, più tollerabile per i pazienti. Certo, la strada è ancora lunga prima di vederlo in farmacia, ma i risultati sono decisamente incoraggianti! È affascinante vedere come combinando chimica, tecnologia farmaceutica e biologia si possano creare soluzioni innovative per problemi di salute comuni.
Fonte: Springer
